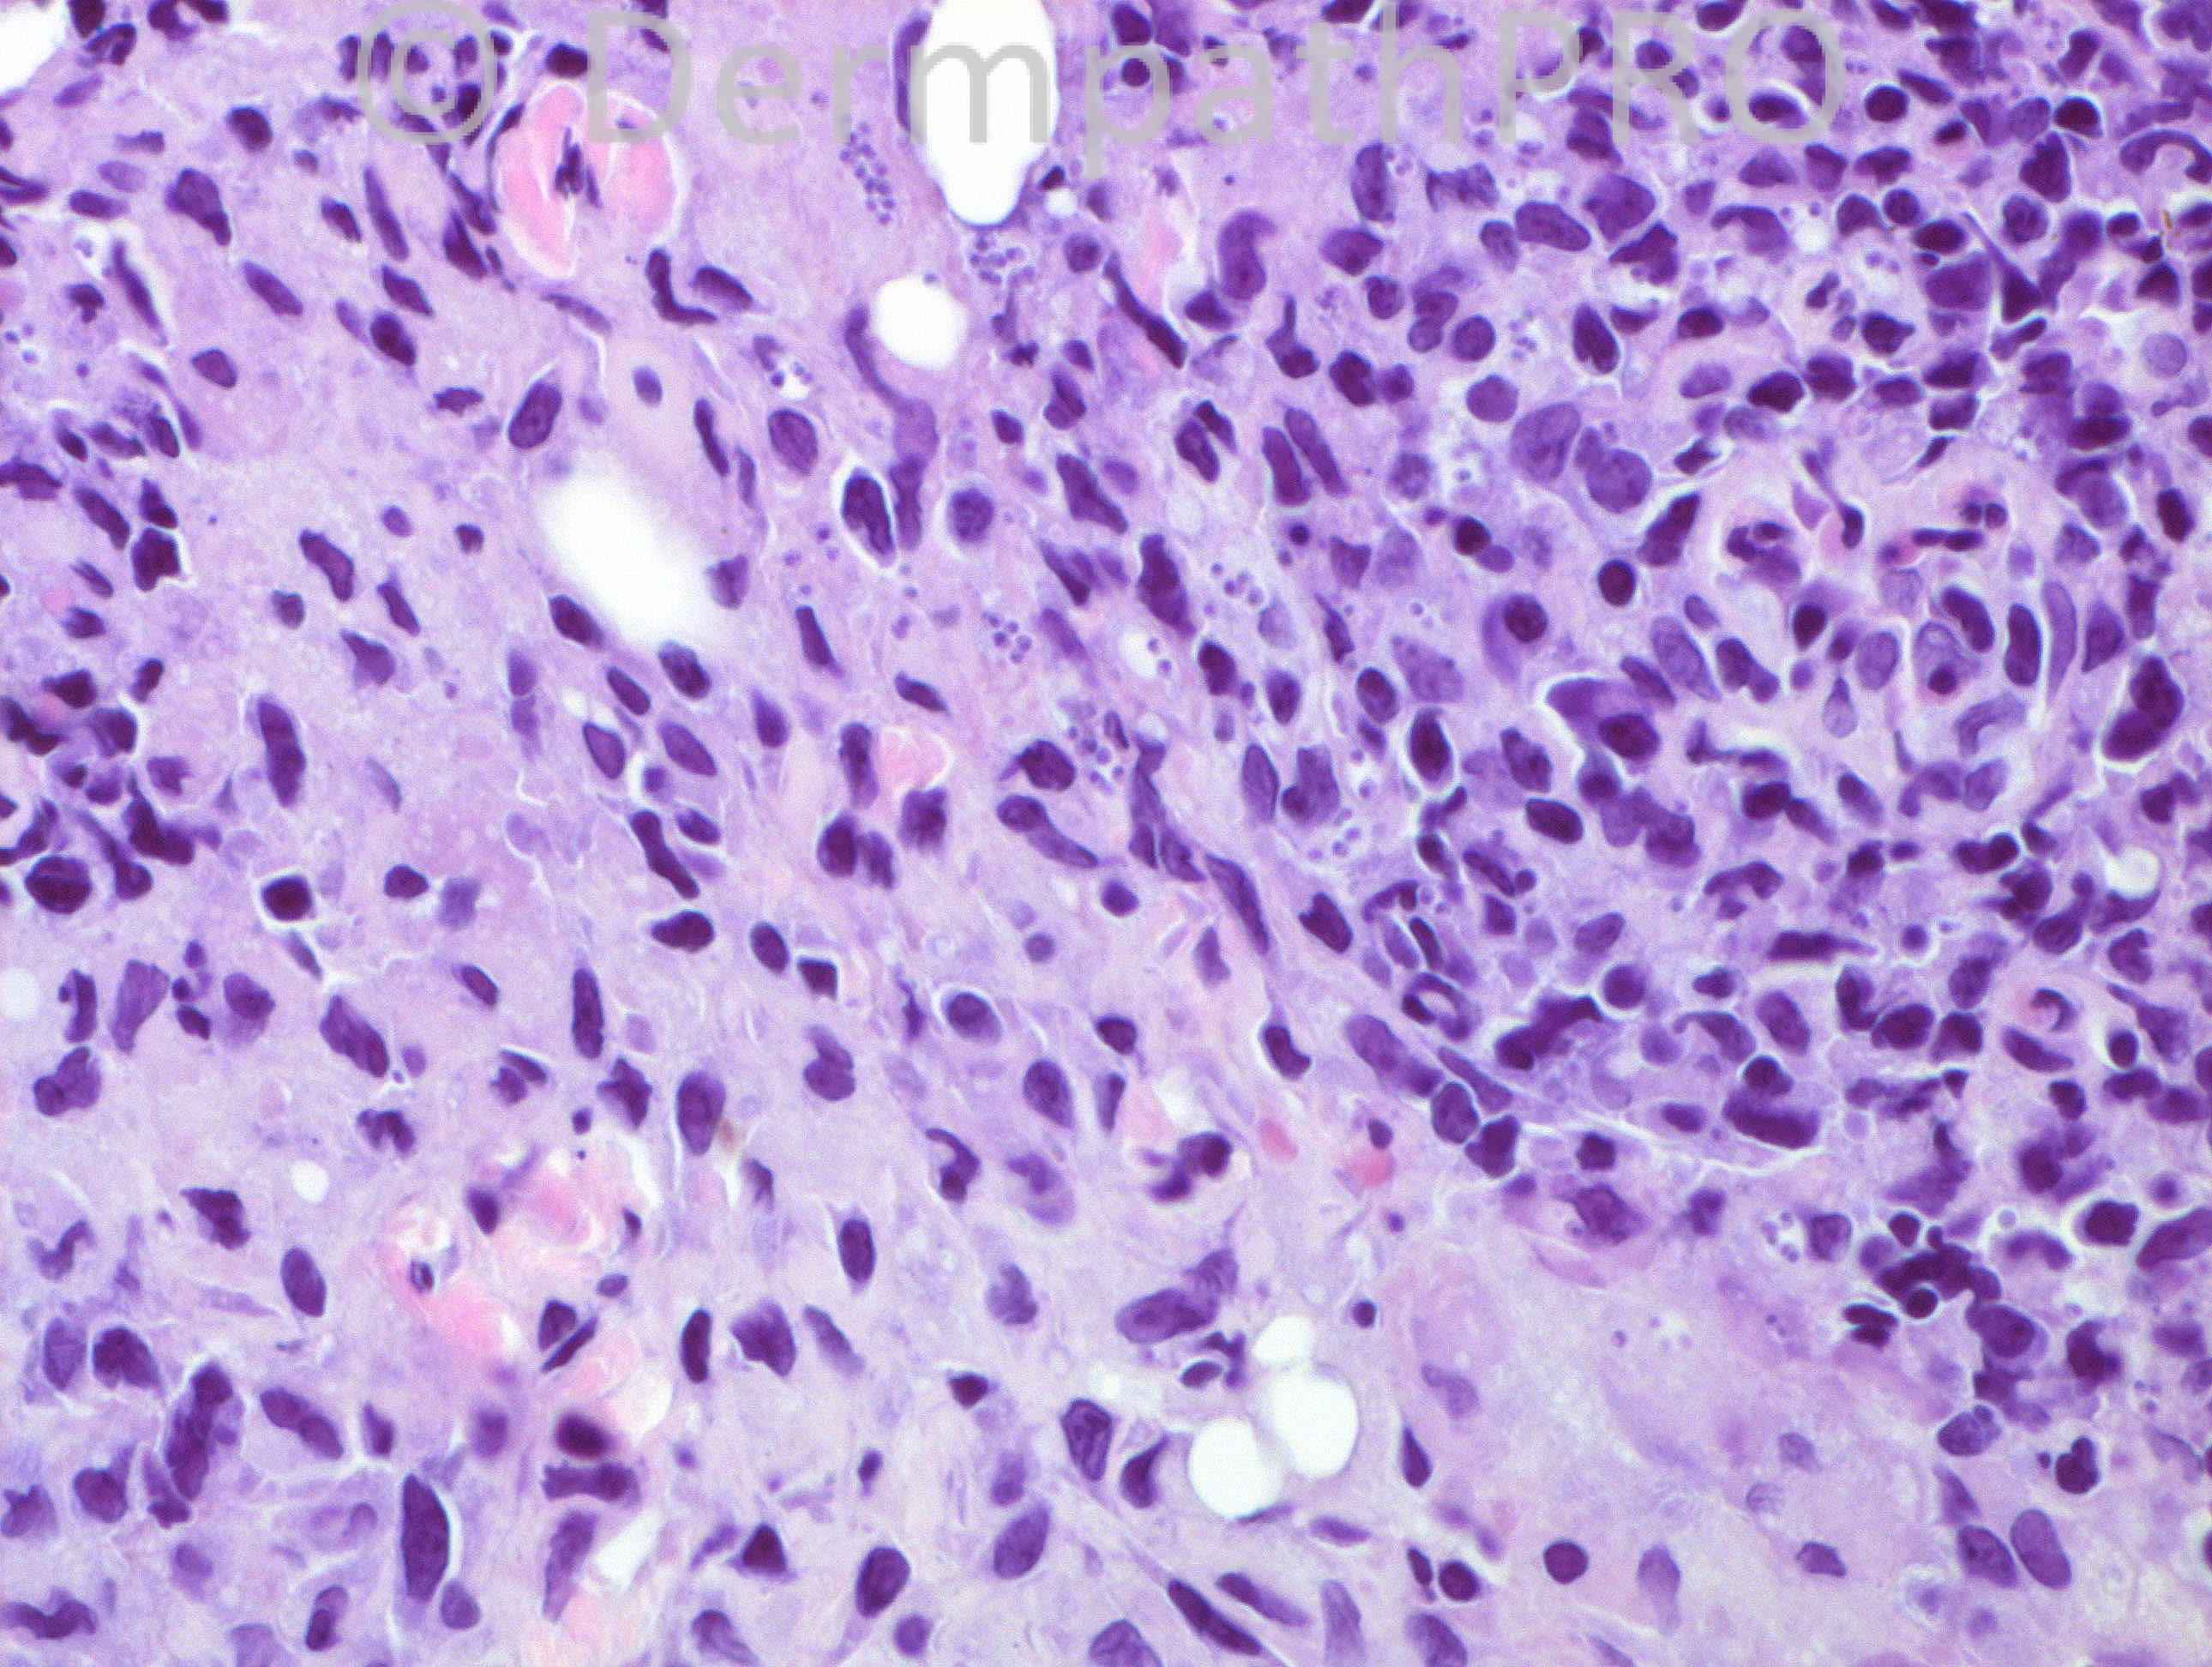

Case Number : Case 710 - 6 Mar Posted By: Guest
Please read the clinical history and view the images by clicking on them before you proffer your diagnosis.
Submitted Date :
43 years-old hispanic male, with a lesion on his scalp. He developed this lesion some time (exact duration not known) after a “bite†by a “large insect†while in a forest.
Case posted by Dr. Hafeez Diwan
Case posted by Dr. Hafeez Diwan

User Feedback